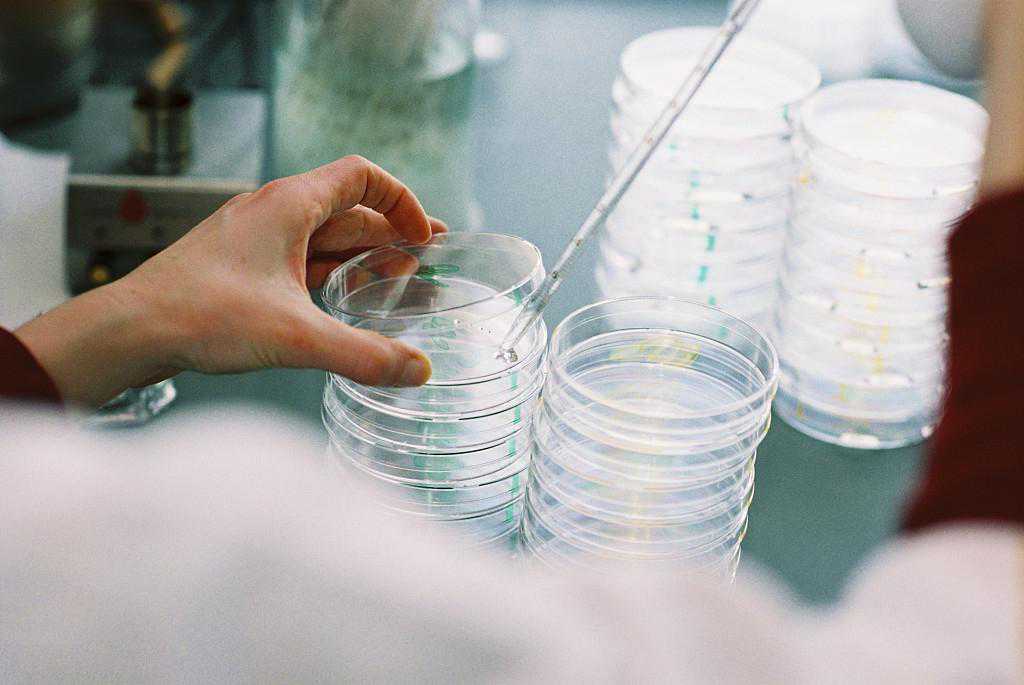

提到试管婴儿就必须要说明一下试管婴儿的由来,试管婴儿是一种体外受精和胚胎移植的技术,这项操作通过人工的方式在体外完成,人工操作成功的受精卵再移植到子宫里,在体外进行受精在子宫中孕育,这种方式被称之为试管婴儿。

有一些因素是会影响到试管婴儿的健康,父母双方的基因是影响孩子健康的关键,不会应为受孕方式的不同而改变孩子的健康和寿命。如果父母自身有遗传疾病,无论是不是试管婴儿,都会影响到孩子的健康。在孕期的一些不良习惯也会应该孩子健康,试管婴儿的成长是在体内完成的,如果母亲有抽烟、喝酒、熬夜等不好的习惯,会影响到胎儿的正常发育。吸烟会对胎儿的大脑发育影响很大,引起脑部异常或功能性障碍。严重的有可能导致流产或早产。
试管婴儿父母的一些感受:
@小橘子:我结婚比较晚,38岁的时候结的婚,婚后想马上要孩子,没想到婚后马上就怀上了,结果到5个月的时候胎停孕了,去医院做了很多检查,结果是我跟老公的染色体有问题,医生建议我们做试管。第一次移植的时候没能成功,第二次终于成功了,现在孩子7个月了,很活泼很健康。

@露丹:我跟老公结婚11年呢,做了3年的试管,一开始觉得做了就能成功,在我身上成功率很低,反反复复做了很多次都没成功,后来做的都麻木了,最后终于成功了,可能是上天的眷顾吧,孩子长的很漂亮,也很健康,是家里的掌上明珠。